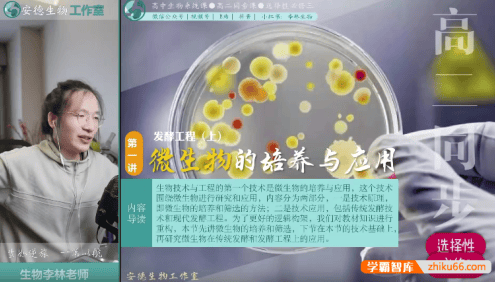
【李林生物】2025届安德高二生物 李林高二生物全年同步课(上学期+下学期)

幸运之星正在降临...
点击领取今天的签到奖励!
恭喜!您今天获得了{{mission.data.mission.credit}}积分
我的优惠劵
-
¥优惠劵使用时效:无法使用使用时效:
之前
使用时效:永久有效优惠劵ID:×
没有优惠劵可用!